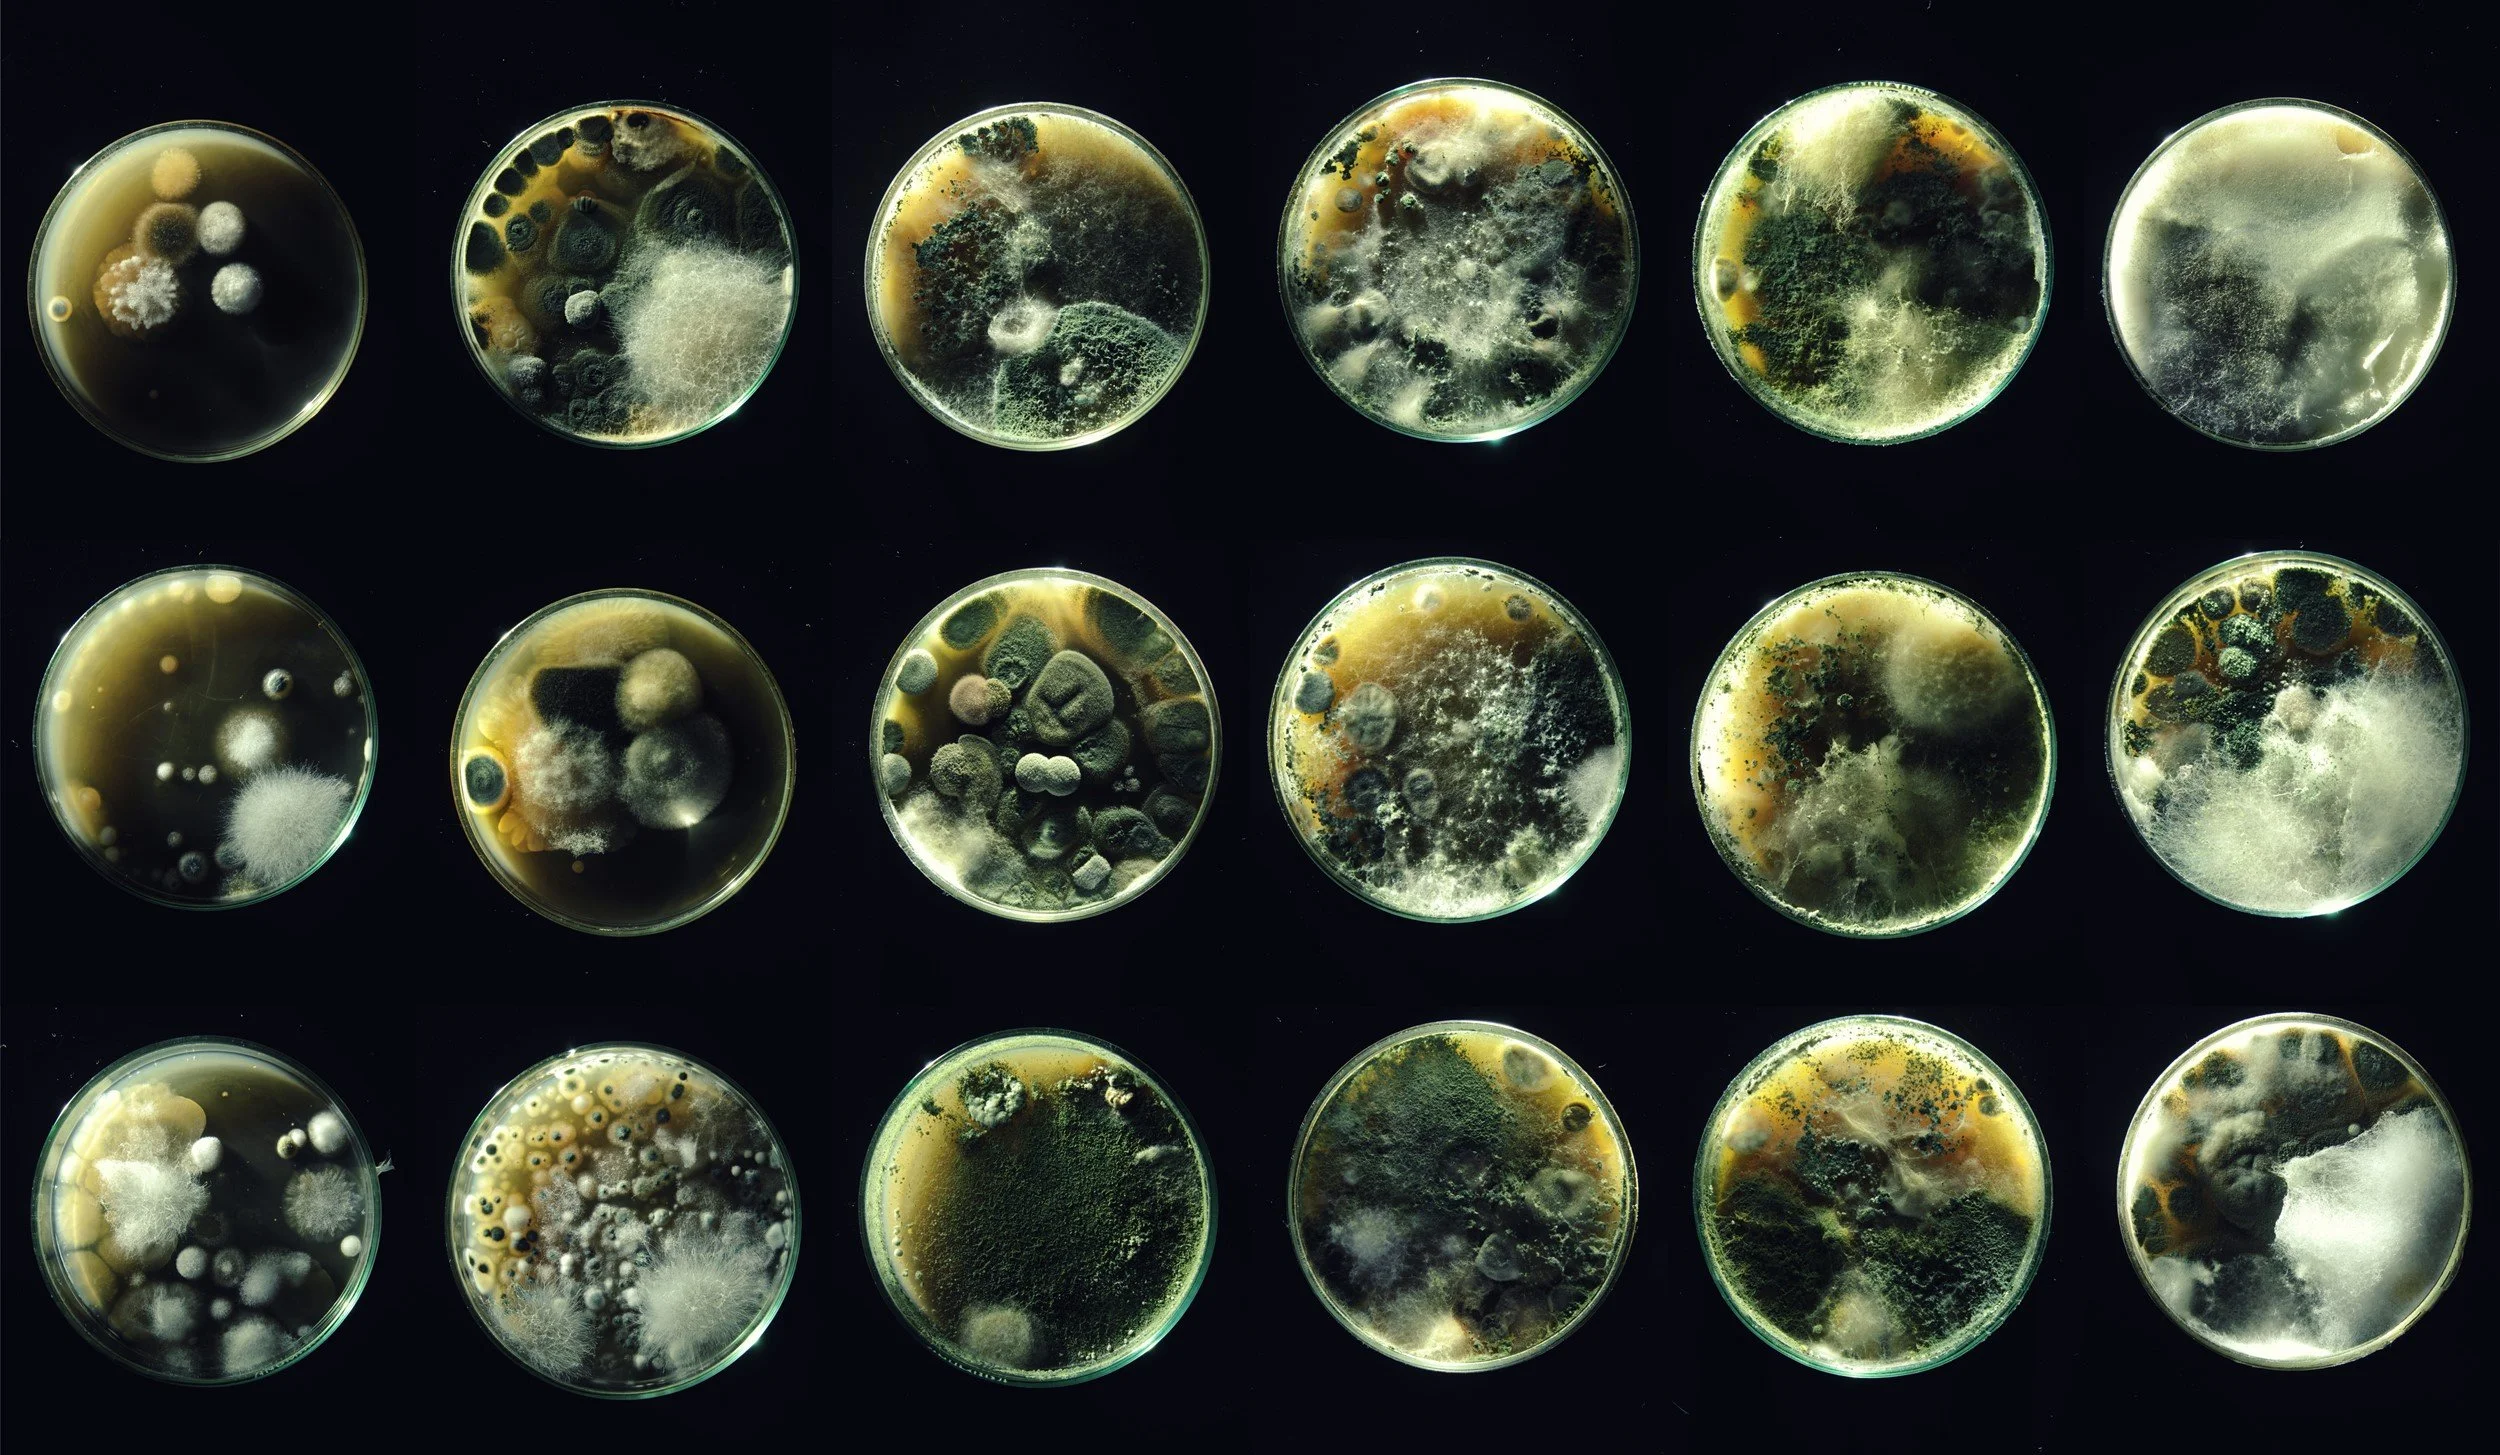

Further design studies (not final) of Reincarnation Kit. At the fair you see an empty Petri dish. We couldn’t bring living organisms in the iconic container through customs. The Petri dish — a planetary circle — is almost swallowed by primal light. Absence becomes part of the grief ritual. Yet absence is never empty. This first Chamber prototype is a vessel for the space before growth, before form. What you see is a place for what could not cross borders, but also for what can never return — or just as equally, can never truly leave
Thank You for finding Reincarnation Kit. We are at BioFab fair to open this project to the world - to invite collaborators, researchers, funders, and future participants who feel the pull of this project to shape it further.
Origin
It all started as a very personal process. I was searching for ways to reincarnate my father (or maybe just to fill that unresolved void of post-suicidal guilt and grief) — not knowing him very well while he was still alive. And I wanted to do it quite literally.
I very much liked the idea that it’s impossible. Well, at least to meet him as he was (that’s for another project — the Time Machine Kit). Another idea struck: together with him we buried an analog film camera. I thought — what could possibly be on that film? Low chances he used it to picture the afterlife, high chances of microorganisms devouring it. Black film with colorful mold.
I just needed to excavate it. Flashlight, some digging equipment, a couple of hours and I would have it in my hands. Quick developing in a darkroom. And here it is — the best piece of art I could ever conceive. Hanging in famous galleries — a long strip of dark film, from place to place eaten up by various organisms.
I don’t need a permit to dig my own father’s grave, yes? What if I hit some bones with a shovel? Police come to arrest me, shamed by my own relatives for such a horrific act. I will definitely document the process — my installation will become very powerful.
All this thinking and these dilemmas became more interesting to me than the act itself. Well, at least for now. Though I did go to the cemetery with some digging equipment and penetrated deep into the layers of my father’s burial place. But I only took some soil.
Thinking: the deeper I go, the more chances that the ecosystem will still have some particles of my father. In some form, at least. I took it to wonderful scientists at the Nature Research Centre, and they gladly carried the process further.
Here I was, looking at dozens of Petri dishes with all kinds of spontaneous shapes. I was looking at my reincarnated father.
What kind of information is there? Do we leave traces of a recognizable “us”? What if I took some microorganisms from my own body and put them inside a dish with my reincarnated father? It’s a reunion, right? We are communicating, growing in one little space, various forms connecting. Do “we” recognize each other? What is “me”?
The lines become very blurry and I hit some very clear limits of perception. And I instantly liked it.
It’s something impossible to prove. But you can still observe it, think about it, take some pictures. It was something primal — language before language.
What it is why it exists
Reincarnation Kit doesn’t follow the usual path of innovation. It doesn’t promise speed, scale, or solutions. What you see in fair is raw, first ritual fragments. Imperfect, unfinished, unresolved. And that is the point. Idea is real and it will grow (we will make more subtle watching chambers, box designs) but Reincarnation Kit moves differently — more like a ritual than a product, more like a question than an answer. It doesn’t measure itself by usefulness. Instead, it creates a space where grief, memory, and transformation can be held without needing to be solved. By the world’s usual measures, Reincarnation Kit is not useful. And maybe that’s exactly why it matters. Because grief, memory, and ritual aren’t efficient. They can’t be reduced to outcomes. They are human. They are alive.
The Reincarnation Kit does not promise comfort. It may not heal you. It may even sadden you. There is no clear result, no quick reward. And that is why it matters. Grief cannot be optimized. Ritual cannot be rushed. This project does not search for progress or innovation. It is a way of summoning something older — a gesture back toward the gods, the myths, the circles we once shared.
The Grief Library
The Reincarnation Kit begins as a personal ritual. But when many people hold it, something larger can emerge: a shared space. The Grief Library is that future. A communal field where the traces of grief, joy, and memory can be gathered. A place to leave fragments — images, words, Petri reincarnations — and to find the fragments of others. It is not a new invention, but a return. Once, myths and rituals gave us a way to face the unknown together. Around fires, in circles, through stories and ceremonies, people shared grief and made meaning in common. Today, though surrounded by technology, we remain clumsy at this. We cope poorly with the rhythms of nature, with the inevitability of loss. The Library gestures back to those communal forms, while carrying them forward in another shape. It will not be an archive of sadness, but a living conversation. A space for the delicate things we often carry alone. The Library does not exist yet. It will grow slowly, through the Kits, through those who take part.
More than one story
The Petri dish is the key metaphor. You open it anywhere, and something grows. It could be grief, it could be memory, it could be curiosity, it could be play. The Kit works at many scales. For one person, it’s a ritual to mourn. For another, it’s the quiet joy of watching soil bloom. For children, it can be a way into nature’s vast interconnectivity — not only our human limits of life or death. Spores are everywhere in the air: you don’t even need to add soil. Open the dish, close it, and something will appear from nothing. For a philosopher, it becomes a vessel for myth. For a scientist, a symbolic piece of bio-art. There is no single meaning. The Kit holds space for all of them. It’s a sincere invitation - a field of entrances, where myth, grief, biology, and play are allowed to entangle.
Support the Reincarnation Kit
The Reincarnation Kit is still in its early stages. What you see in London are fragile prototypes — enough to show the idea, not yet enough to hold it fully.
If the project resonates with you, you can help it grow. Support isn’t about buying a finished object, but about joining the process and allowing the next form to emerge.
All ongoing updates, experiments, and ways to support live on the Reincarnation Kit Substack — a working space and archive as the project takes shape.
You can support Reincarnation Kit here:
Reincarnation Kit
Reincarnate Your Loved Ones
First tests of Reincarnations: father as bacteria, bacteria as father
Father as fungi, fungi as father
Father as bacteria, bacteria as father II
Father as fungi, fungi as father II
How To Transfer Yourself To The Otherworld
Spontaneous caligraphy in Petri dish with reincarnated father appears - letter T (in Lithuanian Tevas means father)
Instruction For (Radical) Dialogue When One Is Dead And Another Is No Longer Human
Reincarnation Watching Chamber
18 versions of Reincarnated father
Dried up worlds
We need to talk how reincarnated will die (or not) again
Grief Library
Reincarnation Watching Chamber variation no. 1
Reincarnation Watching Chamber variation no. 2 (Petri dish visible only from top)
Reincarnation Watching Chamber variation no. 2
Reincarnation Kit box design variation no. 1
Reincarnation Kit box design variation no. 3
Reincarnation Kit box design variation no. 2
Porous existence, neverending metamorphosis: Father as father (1972) / Father as bacteria and fungi, bacteria and fungi as father (2022)